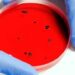
ALERTA SANITARIA POR KLEBSIELLA OXYTOCA EN EDOMEX 7 ALERTA SANITARIA POR KLEBSIELLA OXYTOCA EN EDOMEX

En la Jornada 14 de la Premier League, Arsenal enfrentará a Manchester United en el Emirates Stadium, buscando consolidarse en puestos de Champions League y recortar puntos al líder Liverpool. Sin embargo, Gabriel Magalhães y Riccardo Calafiori no estarán disponibles debido a lesiones de último momento.
Reemplazos confirmados: Jakub Kiwior ocupará la defensa central junto a William Saliba, mientras que Oleksandr Zinchenko cubrirá el lateral izquierdo.
Alineación del Arsenal: Raya; Timber, Saliba, Kiwior, Zinchenko; Odegaard, Partey, Rice; Saka, Havertz y Martinelli.
#PremierLeague #Arsenal #ManchesterUnited